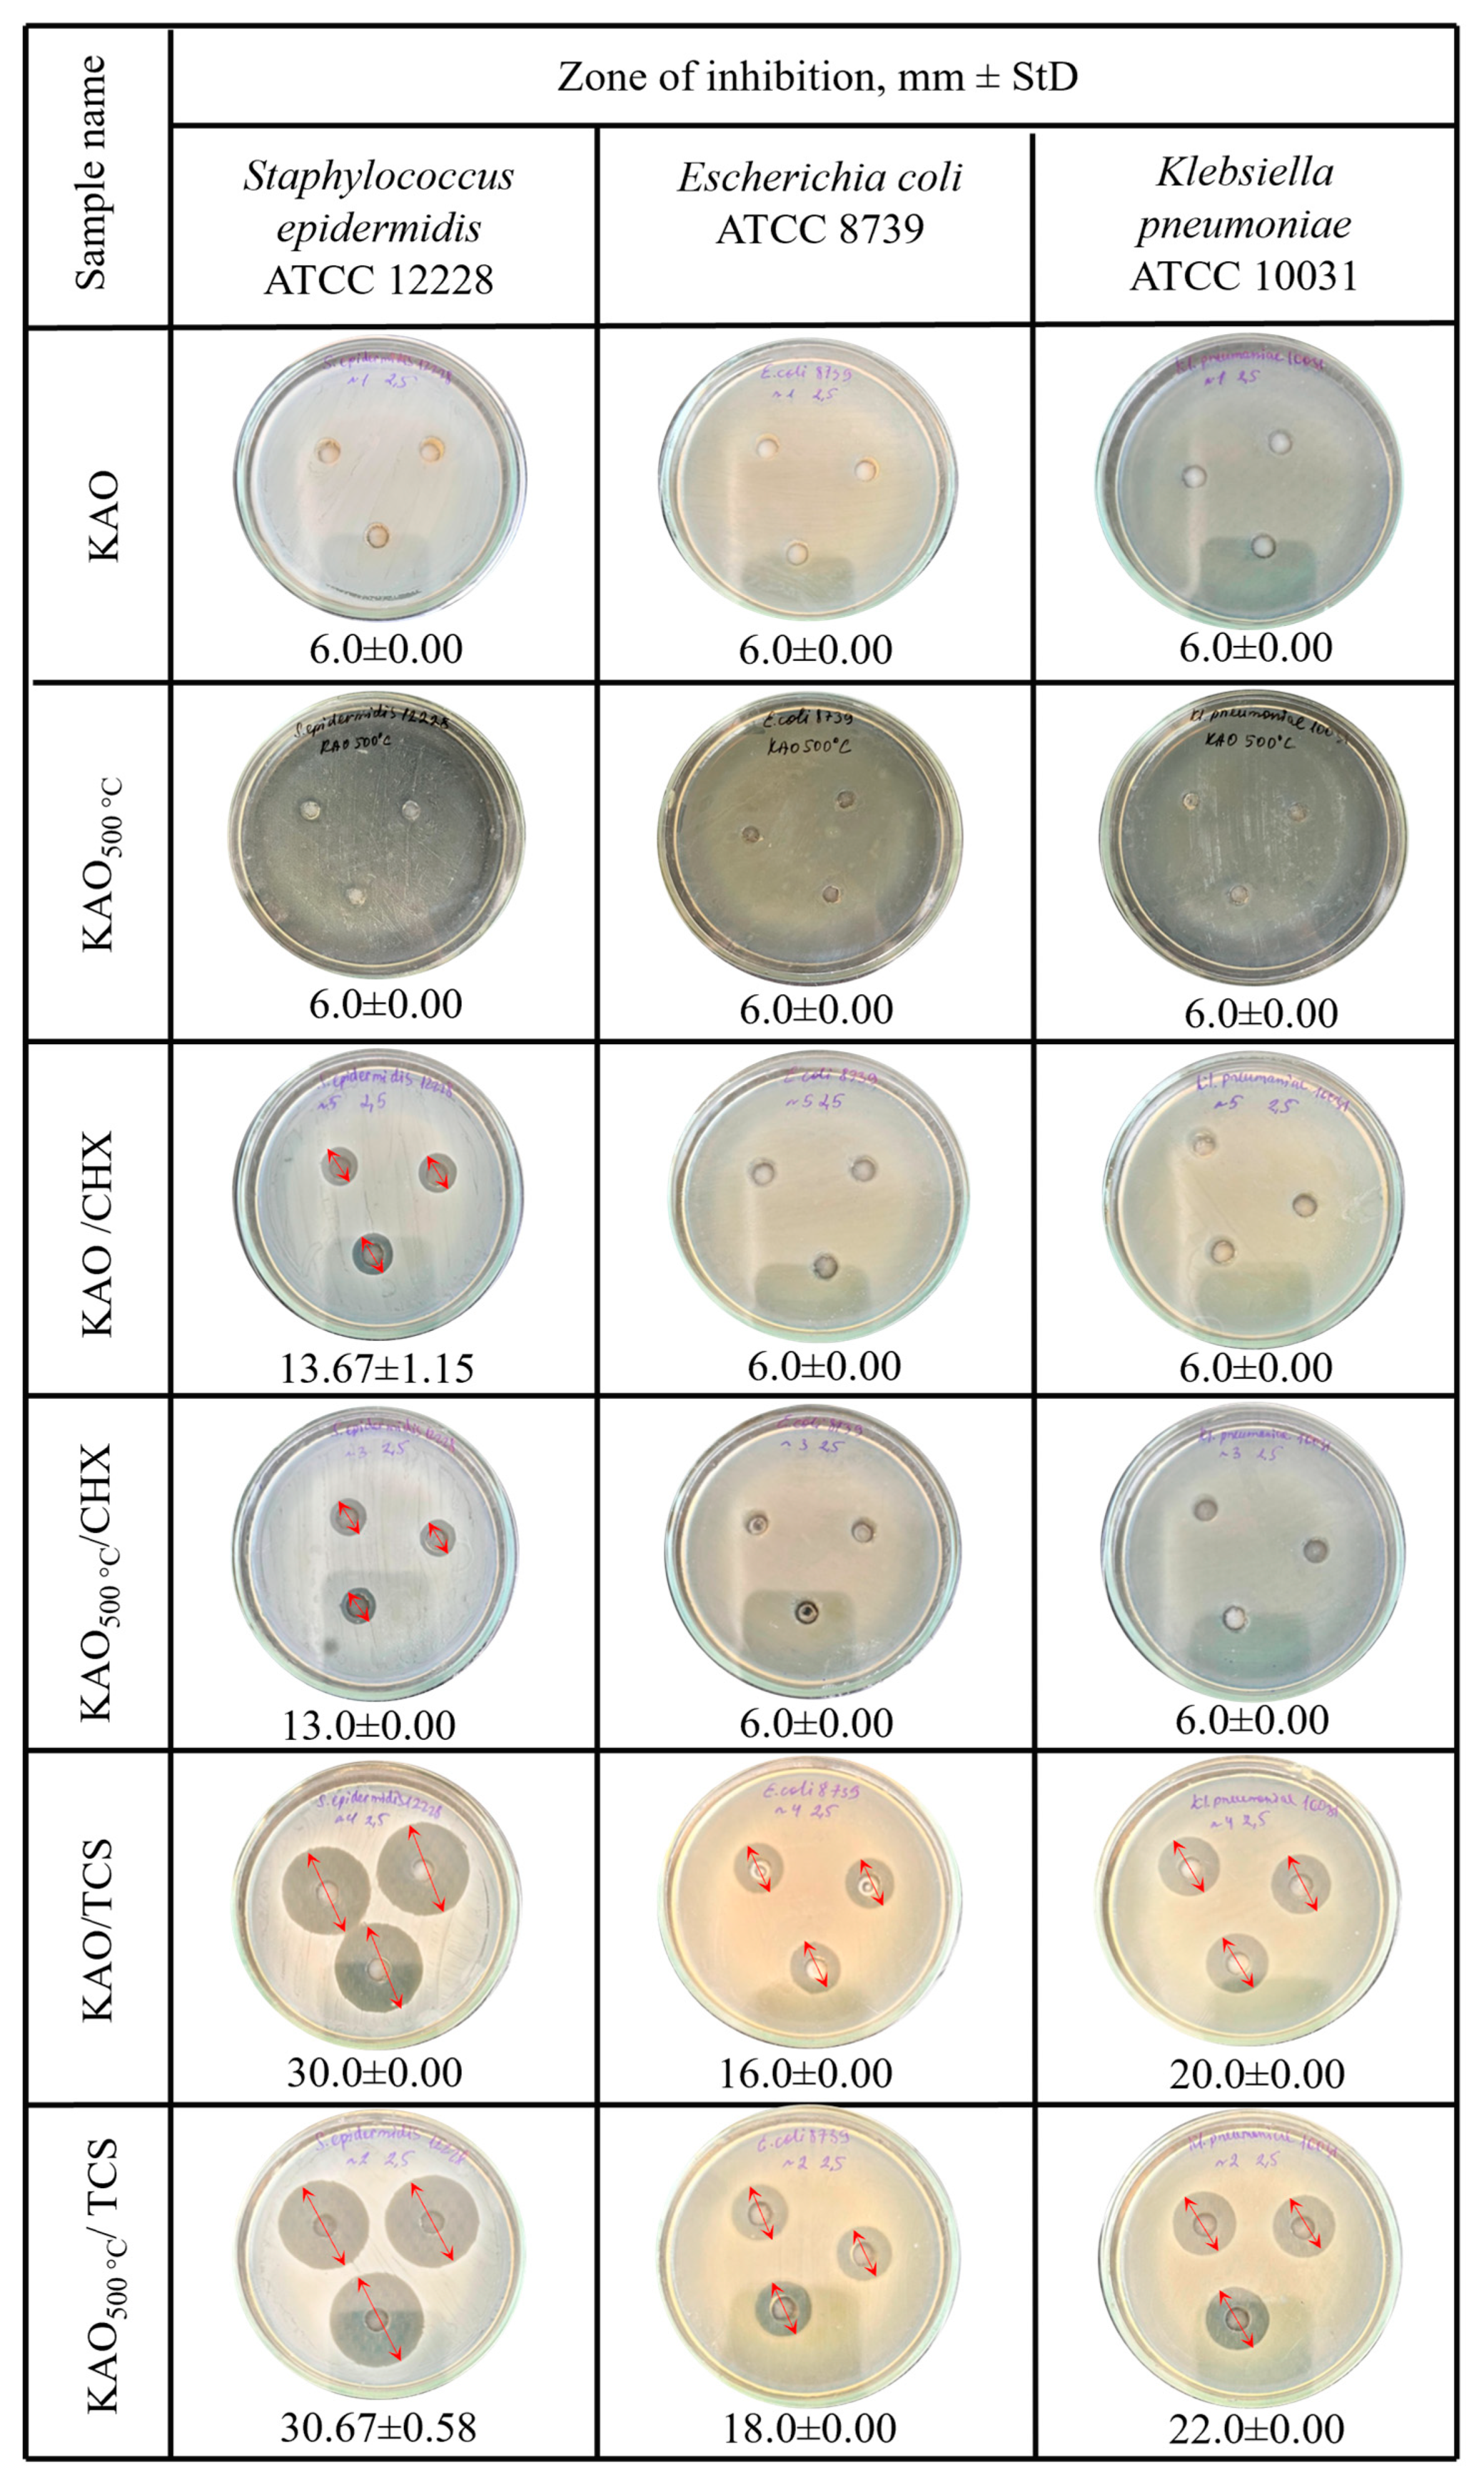

Synthesis and Antibacterial Evaluation of Chlorhexidine- and Triclosan-Impregnated Kaolinite Nanocomposites
Abstract
1. Introduction
2. Materials and Methods
2.1. The Process of Preparation of the Chlorhexidine/Kaolin, Triclosan/Kaolin Composites
- (1)
- KAO500 is a natural kaolinite sample that was pre-washed with distilled water, dried at 100 °C, and then calcined for 5 h in a muffle furnace at 500 °C.
- (2)
- KAO/CHX is a composite based on natural kaolinite dried at 100 °C and impregnated with the antibacterial agent chlorhexidine digluconate (CHX).
- (3)
- KAO500/CHX is a composite based on natural kaolinite dried at 100 °C and calcined at 500 °C for 5 h and impregnated with the antibacterial agent chlorhexidine digluconate (CHX).
- (4)
- KAO/TCS is a composite based on natural kaolinite dried at 100 °C and impregnated with the antibacterial agent triclosan.
- (5)
- KAO500/TCS is a composite based on natural kaolinite dried at 100 °C and calcined at 500 °C and impregnated with the antibacterial agent triclosan.
2.2. Methods and Instrumental Characterization
2.3. Antimicrobial Assay of Kaolinite/Chlorhexidine and Kaolinite/Triclosan Composites
3. Results
3.1. Characterization of Natural Kaolinite
3.2. SEM and SEM-EDX Analysis of Kaolinite/Chlorhexidine and Kaolinite/Triclosan Composites
3.3. FTIR Analysis of Kaolinite/Chlorhexidine and Kaolinite/Triclosan Composites
3.4. Powder X-Ray Diffraction Analysis of Chlorhexidine/Kaolin and Triclosan/Kaolin Composites
3.5. Antibacterial Activity
4. Conclusions
Author Contributions
Funding
Institutional Review Board Statement
Informed Consent Statement
Data Availability Statement
Conflicts of Interest
References
- Holešová, S.; Valášková, M.; Plevová, E.; Pazdziora, E.; Matějová, K. Preparation of novel organovermiculites with antibacterial activity using chlorhexidine diacetate. J. Colloid Interface Sci. 2010, 342, 593–597. [Google Scholar] [CrossRef]
- Gil, A.; Santamaría, L.; Korili, S.A.; Vicente, M.A.; Barbosa, L.V.; De Souza, S.D.; Ciuffi, K.J. A review of organic-inorganic hybrid clay based adsorbents for contaminants removal: Synthesis, perspectives and applications. J. Environ. Chem. Eng. 2021, 9, 105808. [Google Scholar] [CrossRef]
- BKG, T.; Yuan, G.; Hashizume, H. Clay minerals and polymers: From soils to nanocomposites. Clay Sci. 2005, 12 (Suppl. 1), 69–73. [Google Scholar] [CrossRef]
- Goh, P.S.; Ismail, A.F.; Sanip, S.M.; Ng, B.C.; Aziz, M. Recent advances of inorganic fillers in mixed matrix membrane for gas separation. Sep. Purif. Technol. 2011, 81, 243–264. [Google Scholar] [CrossRef]
- Siraj, S.; Al-Marzouqi, A.H.; Iqbal, M.Z.; Ahmed, W. Impact of micro silica filler particle size on mechanical properties of polymeric based composite material. Polymers 2022, 14, 4830. [Google Scholar] [CrossRef] [PubMed]
- Yükselen, Y. Specific Surface Area and Pore Size Distribution Effect on Engineering Properties of Fine-Grained Soils. Ph.D. Thesis, Dokuz Eylul Universitesi, Izmir, Turkey, 2007. [Google Scholar]
- Kuila, U.; Prasad, M. Surface area and pore-size distribution in clays and shales. In Proceedings of the SPE Annual Technical Conference and Exhibition, Denver, CO, USA, 30 October–2 November 2011; p. SPE-146869. [Google Scholar]
- Nadeau, P.H. The physical dimensions of fundamental clay particles. Clay Miner. 1985, 20, 499–514. [Google Scholar] [CrossRef]
- Leong, Y.W.; Abu Bakar, M.B.; Ishak, Z.M.; Ariffin, A.; Pukanszky, B. Comparison of the Mechanical Properties and Interfacial Interactions Between Talc, Kaolin, and Calcium Carbonate Filled Polypropylene Composites. J. Appl. Polym. Sci. 2004, 91, 3315–3326. [Google Scholar] [CrossRef]
- Fernandez, M.A.; Bellotti, N. Silica-Based Bioactive Solids Obtained from Modified Diatomaceous Earth to Be Used as Antimicrobial Filler Material. Mater. Lett. 2017, 194, 130–134. [Google Scholar] [CrossRef]
- Fernandez, R.; Martirena, F.; Scrivener, K.L. The Origin of the Pozzolanic Activity of Calcined Clay Minerals: A Comparison Between Kaolinite, Illite, and Montmorillonite. Cem. Concr. Res. 2011, 41, 113–122. [Google Scholar] [CrossRef]
- Longkaew, K.; Gibaud, A.; Tessanan, W.; Daniel, P.; Phinyocheep, P. Spherical CaCO3: Synthesis, Characterization, Surface Modification, and Efficacy as a Reinforcing Filler in Natural Rubber Composites. Polymers 2023, 15, 4287. [Google Scholar] [CrossRef] [PubMed]
- Kim, M.H.; Choi, G.; Elzatahry, A.; Vinu, A.; Choy, Y.B.; Choy, J.H. Review of Clay-Drug Hybrid Materials for Biomedical Applications: Administration Routes. Clays Clay Miner. 2016, 64, 115–130. [Google Scholar] [CrossRef] [PubMed]
- Rakhmatullayeva, D.; Ospanova, A.; Bekissanova, Z.; Jumagaziyeva, A.; Savdenbekova, B.; Seidulayeva, A.; Sailau, A. Development and Characterization of Antibacterial Coatings on Surgical Sutures Based on Sodium Carboxymethyl Cellulose/Chitosan/Chlorhexidine. Int. J. Biol. Macromol. 2023, 236, 124024. [Google Scholar] [CrossRef] [PubMed]
- Savdenbekova, B.; Seidulayeva, A.; Sailau, A.; Bekissanova, Z.; Rakhmatullayeva, D.; Jumagaziyeva, A. Investigation of Antibacterial Coatings Based on Chitosan/Polyacrylic Acid/Chlorhexidine for Orthopedic Implants. ACS Polym. Au 2024, 4, 460–549. [Google Scholar] [CrossRef] [PubMed]
- Carretero, M.I. Clay Minerals and Their Beneficial Effects upon Human Health: A Review. Appl. Clay Sci. 2002, 21, 155–163. [Google Scholar] [CrossRef]
- Aguzzi, C.; Cerezo, P.; Viseras, C.; Caramella, C. Use of Clays as Drug Delivery Systems: Possibilities and Limitations. Appl. Clay Sci. 2007, 36, 22–36. [Google Scholar] [CrossRef]
- Viseras, C.; Carazo, E.; Borrego-Sánchez, A.; García-Villén, F.; Sánchez-Espejo, R.; Cerezo, P.; Aguzzi, C. Clay Minerals in Skin Drug Delivery. Clays Clay Miner. 2019, 67, 59–71. [Google Scholar] [CrossRef]
- Beringhs, A.O.R.; Rosa, J.M.; Stulzer, H.K.; Budal, R.M.; Sonaglio, D. Green Clay and Aloe Vera Peel-Off Facial Masks: Response Surface Methodology Applied to the Formulation Design. AAPS PharmSciTech 2013, 14, 445–455. [Google Scholar] [CrossRef] [PubMed]
- López-Galindo, A.; Viseras, C.; Cerezo, P. Compositional, Technical, and Safety Specifications of Clays to Be Used as Pharmaceutical and Cosmetic Products. Appl. Clay Sci. 2007, 36, 51–63. [Google Scholar] [CrossRef]
- Chávez-Delgado, M.E.; Kishi-Sutto, C.V.; de la Riva, X.N.A.; Rosales-Cortes, M.; Gamboa-Sánchez, P. Topic Usage of Kaolin-Impregnated Gauze as a Hemostatic in Tonsillectomy. J. Surg. Res. 2014, 192, 678–685. [Google Scholar] [CrossRef]
- Carretero, M.I.; Gomes, C.S.F.; Tateo, F. Clays and Human Health. Dev. Clay Sci. 2006, 1, 717–741. [Google Scholar] [CrossRef]
- Carretero, M.I.; Pozo, M.; Martín-Rubí, J.A.; Pozo, E.; Maraver, F. Mobility of Elements in Interaction Between Artificial Sweat and Peloids Used in Spanish Spas. Appl. Clay Sci. 2010, 48, 506–515. [Google Scholar] [CrossRef]
- Moraes, J.D.D.; Bertolino, S.R.A.; Cuffini, S.L.; Ducart, D.F.; Bretzke, P.E.; Leonardi, G.R. Clay Minerals: Properties and Applications to Dermocosmetic Products and Perspectives of Natural Raw Materials for Therapeutic Purposes—A Review. Int. J. Pharm. 2017, 534, 213–219. [Google Scholar] [CrossRef] [PubMed]
- Awad, M.E.; López-Galindo, A.; Setti, M.; El-Rahmany, M.M.; Iborra, C.V. Kaolinite in Pharmaceutics and Biomedicine. Int. J. Pharm. 2017, 533, 34–48. [Google Scholar] [CrossRef]
- Viseras, C.; Cerezo, P.; Sanchez, R.; Salcedo, I.; Aguzzi, C. Current Challenges in Clay Minerals for Drug Delivery. Appl. Clay Sci. 2010, 48, 291–295. [Google Scholar] [CrossRef]
- Isah, M.; Shagari, A.B.; Usman, H.M. Antibacterial and Dye Removal Potential of Modified Kaolinite for the Treatment of Drinking Water. Plant Biotechnol. Persa 2022, 4, 75–87. [Google Scholar] [CrossRef]
- Malek, N.A.N.N.; Azalisa, W.N.; Lin, C.C.Y. Antibacterial Activity of Cetyltrimethylammonium Bromide Modified Silver-Bentonite. MATEC Web Conf. 2016, 60, 03005. [Google Scholar] [CrossRef]
- Saad, N.S.S.M.; Malek, N.A.N.N.; Chong, C.S. Antimicrobial Activity of Copper Kaolinite and Surfactant Modified Copper Kaolinite Against Gram Positive and Gram Negative Bacteria. J. Teknol. 2016, 78. [Google Scholar] [CrossRef]
- Demirci, S.; Ustaoğlu, Z.; Yılmazer, G.A.; Sahin, F.; Baç, N. Antimicrobial Properties of Zeolite-X and Zeolite-A Ion-Exchanged with Silver, Copper, and Zinc Against a Broad Range of Microorganisms. Appl. Biochem. Biotechnol. 2014, 172, 1652–1662. [Google Scholar] [CrossRef]
- Shu, Z.; Zhang, Y.; Yang, Q.; Yang, H. Halloysite Nanotubes Supported Ag and ZnO Nanoparticles with Synergistically Enhanced Antibacterial Activity. Nanoscale Res. Lett. 2017, 12, 135. [Google Scholar] [CrossRef]
- Malek, N.A.N.N.; Ramli, N.I.A. Characterization and Antibacterial Activity of Cetylpyridinium Bromide (CPB) Immobilized on Kaolinite with Different CPB Loadings. Appl. Clay Sci. 2015, 109, 8–14. [Google Scholar] [CrossRef]
- Besinis, A.; De Peralta, T.; Handy, R.D. The Antibacterial Effects of Silver, Titanium Dioxide, and Silica Dioxide Nanoparticles Compared to the Dental Disinfectant Chlorhexidine on Streptococcus mutans Using a Suite of Bioassays. Nanotoxicology 2014, 8, 1–16. [Google Scholar] [CrossRef] [PubMed]
- Malek, N.A.N.N.; Ramli, N.I.A. Preparation and Antibacterial Properties of Cetylpyridinium Bromide-Modified Silver-Loaded Kaolinite. Mater. Res. Express 2019, 6, 094006. [Google Scholar] [CrossRef]
- Jou, S.K.; Malek, N.A.N.N. Characterization and Antibacterial Activity of Chlorhexidine Loaded Silver-Kaolinite. Appl. Clay Sci. 2016, 127–128, 1–9. [Google Scholar] [CrossRef]
- Holešová, S.; Valášková, M.; Hlaváč, D.; Madejová, J.; Samlíková, M.; Tokarský, J.; Pazdziora, E. Antibacterial Kaolinite/Urea/Chlorhexidine Nanocomposites: Experiment and Molecular Modelling. Appl. Surf. Sci. 2014, 305, 783–791. [Google Scholar] [CrossRef]
- Ding, S.L.; Zhang, L.L.; Xu, B.H.; Liu, Q.F. Review and Prospect of Surface Modification of Kaolin. Adv. Mater. Res. 2012, 430, 1382–1385. [Google Scholar] [CrossRef]
- Tamer, M.T.; Alsehli, M.H.; Omer, A.M.; Afifi, T.H.; Sabet, M.M.; Mohy-Eldin, M.S.; Hassan, M.A. Development of Polyvinyl Alcohol/Kaolin Sponges Stimulated by Marjoram as Hemostatic, Antibacterial, and Antioxidant Dressings for Wound Healing Promotion. Int. J. Mol. Sci. 2021, 22, 13050. [Google Scholar] [CrossRef]
- Nayak, P.S.; Singh, B.K. Instrumental Characterization of Clay by XRF, XRD, and FTIR. Bull. Mater. Sci. 2007, 30, 235–238. [Google Scholar] [CrossRef]
- Panda, A.K.; Mishra, B.G.; Mishra, D.K.; Singh, R.K. Effect of Sulphuric Acid Treatment on the Physico-Chemical Characteristics of Kaolin Clay. Colloids Surf. A Physicochem. Eng. Asp. 2010, 363, 98–104. [Google Scholar] [CrossRef]
- Henych, J.; Štengl, V. Feasible Synthesis of TiO2 Deposited on Kaolin for Photocatalytic Applications. Clays Clay Miner. 2013, 61, 165–176. [Google Scholar] [CrossRef]
- Srasra, E.; Bergaya, F.; Fripiat, J.J. Infrared spectroscopy study of tetrahedral and octahedral substitutions in an interstratified illite-smectite clay. Clays Clay Miner. 1994, 42, 237–241. [Google Scholar] [CrossRef]
- Au, P.I.; Leong, Y.K. Rheological and Zeta Potential Behaviour of Kaolin and Bentonite Composite Slurries. Colloids Surf. A Physicochem. Eng. Asp. 2013, 436, 530–541. [Google Scholar] [CrossRef]
- Fabbri, B.; Gualtieri, S.; Leonardi, C.J.A.C.S. Modifications Induced by the Thermal Treatment of Kaolin and Determination of Reactivity of Metakaolin. Appl. Clay Sci. 2013, 73, 2–10. [Google Scholar] [CrossRef]
- Madejová, J.; Janek, M.; Komadel, P.; Herbert, H.J.; Moog, H.C. FTIR analyses of water in MX-80 bentonite compacted from high salinary salt solution systems. Appl. Clay Sci. 2002, 20, 255–271. [Google Scholar] [CrossRef]
- Grim, R.E. Clay Mineralogy: The Clay Mineral Composition of Soils and Clays is Providing an Understanding of Their Properties. Science 1962, 135, 890–898. [Google Scholar] [CrossRef] [PubMed]
- Ma, C.; Eggleton, R.A. Cation Exchange Capacity of Kaolinite. Clays Clay Miner. 1999, 47, 174–180. [Google Scholar] [CrossRef]
- Yin, H.; Liu, H.; Bu, Y.; Chen, W.; Ding, F.; Lin, W.; Zhang, Y. Regulation of Reactivity of Calcined Ultrafine Kaolin Products. Processes 2024, 12, 2268. [Google Scholar] [CrossRef]
- Sabah, E.; Turan, M.; Celik, M.S. Adsorption Mechanism of Cationic Surfactants onto Acid- and Heat-Activated Sepiolites. Water Res. 2002, 36, 3957–3964. [Google Scholar] [CrossRef]
- Yang, D.; Yuan, P.; Zhu, J.X.; He, H.P. Synthesis and characterization of antibacterial compounds using montmorillonite and chlorhexidine acetate. J. Therm. Anal. Calorim. 2007, 89, 847–852. [Google Scholar] [CrossRef]
- Lobato-Aguilar, H.; Uribe-Calderón, J.A.; Herrera-Kao, W.; Duarte-Aranda, S.; Baas-López, J.M.; Escobar-Morales, B.; Cervantes-Uc, J.M. Synthesis, Characterization and Chlorhexidine Release from Either Montmorillonite or Palygorskite Modified Organoclays for Antibacterial Applications. J. Drug Deliv. Sci. Technol. 2018, 46, 452–460. [Google Scholar] [CrossRef]
- Celebioglu, A.; Umu, O.C.; Tekinay, T.; Uyar, T. Antibacterial Electrospun Nanofibers from Triclosan/Cyclodextrin Inclusion Complexes. Colloids Surf. B Biointerfaces 2014, 116, 612–619. [Google Scholar] [CrossRef]
- Wang, S.; Zuo, X.; Cheng, H.; Yang, Y.; Liu, Q. Structural Model and De-Intercalation Kinetics of Kaolinite-Methanol-Sodium Stearate Intercalation Compound. J. Braz. Chem. Soc. 2016, 27, 1311–1318. [Google Scholar] [CrossRef]
- Varga, G. The structure of kaolinite and metakaolinite. Epitoanyag 2007, 59, 6–9. [Google Scholar] [CrossRef]
- Hanim, S.A.M.; Malek, N.A.N.N.; Ibrahim, Z. Amine-Functionalized, Silver-Exchanged Zeolite NaY: Preparation, Characterization and Antibacterial Activity. Appl. Surf. Sci. 2016, 360, 121–130. [Google Scholar] [CrossRef]
- Paladini, F.; Pollini, M. Antimicrobial Silver Nanoparticles for Wound Healing Application: Progress and Future Trends. Materials 2019, 12, 2540. [Google Scholar] [CrossRef]
- Holešová, S.; Samlíková, M.; Pazdziora, E.; Valášková, M. Antibacterial Activity of Organomontmorillonites and Organovermiculites Prepared Using Chlorhexidine Diacetate. Appl. Clay Sci. 2013, 83, 17–23. [Google Scholar] [CrossRef]
- Kamalipour, J.; Masoomi, M.; Khonakdar, H.A.; Razavi, S.M.R. Preparation and Release Study of Triclosan in Polyethylene/Triclosan Anti-Bacterial Blend. Colloids Surf. B Biointerfaces 2016, 145, 891–898. [Google Scholar] [CrossRef]
- Malek, N.A.N.N.; Ishak, S.A.; Kadir, M.R.A. Antibacterial Activity of Copper and CTAB Modified Clays Against Pseudomonas aeruginosa. Adv. Mater. Res. 2013, 626, 178–182. [Google Scholar] [CrossRef]
- Lovo de Carvalho, A.; Ferreira, B.F.; Martins, C.H.G.; Nassar, E.J.; Nakagaki, S.; Machado, G.S.; Ciuffi, K.J. Tetracarboxyphenylporphyrin–Kaolinite Hybrid Materials as Efficient Catalysts and Antibacterial Agents. J. Phys. Chem. C 2014, 118, 24562–24574. [Google Scholar] [CrossRef]
- Holešová, S.; Hundáková, M.; Pazdziora, E. Antibacterial Kaolinite-Based Nanocomposites. Procedia Mater. Sci. 2016, 12, 124–129. [Google Scholar] [CrossRef]
- Ambrogi, V.; Pietrella, D.; Nocchetti, M.; Casagrande, S.; Moretti, V.; De Marco, S.; Ricci, M. Montmorillonite–Chitosan–Chlorhexidine Composite Films with Antibiofilm Activity and Improved Cytotoxicity for Wound Dressing. J. Colloid Interface Sci. 2017, 491, 265–272. [Google Scholar] [CrossRef] [PubMed]
- Chen, H.; Ye, Z.; Sun, L.; Li, X.; Shi, S.; Hu, J.; Wang, B. Synthesis of Chitosan-Based Micelles for pH Responsive Drug Release and Antibacterial Application. Carbohydr. Polym. 2018, 189, 65–71. [Google Scholar] [CrossRef] [PubMed]
- Samlíková, M.; Holešová, S.; Hundáková, M.; Pazdziora, E.; Jankovič, Ľ.; Valášková, M. Preparation of Antibacterial Chlorhexidine/Vermiculite and Release Study. Int. J. Miner. Process. 2017, 159, 1–6. [Google Scholar] [CrossRef]
- Saha, K.; Butola, B.S.; Joshi, M. Synthesis and Characterization of Chlorhexidine Acetate Drug–Montmorillonite Intercalates for Antibacterial Applications. Appl. Clay Sci. 2014, 101, 477–483. [Google Scholar] [CrossRef]
- Abdallah, C. Perioperative Chlorhexidine Allergy: Is It Serious? J. Anaesthesiol. Clin. Pharmacol. 2015, 31, 152–154. [Google Scholar] [CrossRef]

Disclaimer/Publisher’s Note: The statements, opinions and data contained in all publications are solely those of the individual author(s) and contributor(s) and not of MDPI and/or the editor(s). MDPI and/or the editor(s) disclaim responsibility for any injury to people or property resulting from any ideas, methods, instructions or products referred to in the content. |
© 2025 by the authors. Licensee MDPI, Basel, Switzerland. This article is an open access article distributed under the terms and conditions of the Creative Commons Attribution (CC BY) license (https://creativecommons.org/licenses/by/4.0/).
Share and Cite
Alimbek, A.; Bekissanova, Z.; Otegenova, B.; Jumagaziyeva, A.; Zhaksybay, B.B.; Zhumadilova, Y.; Ospanova, A. Synthesis and Antibacterial Evaluation of Chlorhexidine- and Triclosan-Impregnated Kaolinite Nanocomposites. Materials 2025, 18, 174. https://doi.org/10.3390/ma18010174
Alimbek A, Bekissanova Z, Otegenova B, Jumagaziyeva A, Zhaksybay BB, Zhumadilova Y, Ospanova A. Synthesis and Antibacterial Evaluation of Chlorhexidine- and Triclosan-Impregnated Kaolinite Nanocomposites. Materials. 2025; 18(1):174. https://doi.org/10.3390/ma18010174
Chicago/Turabian StyleAlimbek, Aruzhan, Zhanar Bekissanova, Bayansulu Otegenova, Ardak Jumagaziyeva, Bagashar B. Zhaksybay, Yana Zhumadilova, and Alyiya Ospanova. 2025. "Synthesis and Antibacterial Evaluation of Chlorhexidine- and Triclosan-Impregnated Kaolinite Nanocomposites" Materials 18, no. 1: 174. https://doi.org/10.3390/ma18010174
APA StyleAlimbek, A., Bekissanova, Z., Otegenova, B., Jumagaziyeva, A., Zhaksybay, B. B., Zhumadilova, Y., & Ospanova, A. (2025). Synthesis and Antibacterial Evaluation of Chlorhexidine- and Triclosan-Impregnated Kaolinite Nanocomposites. Materials, 18(1), 174. https://doi.org/10.3390/ma18010174

